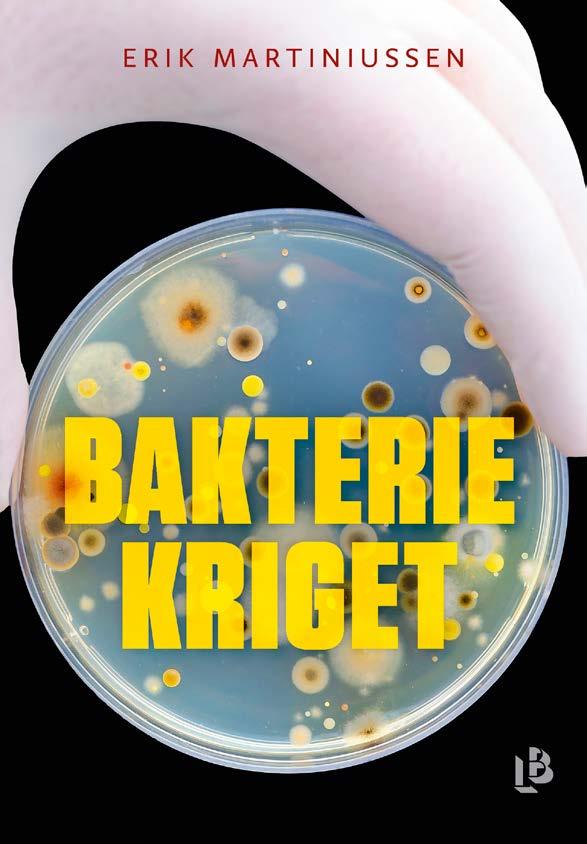

LOUISE BÄCKELIN FÖRLAG
LOUISE BÄCKELIN FÖRLAG
–HÖST 2020

innehåll
Pischa Strindstedt, Paula Rosas: Mamatastic – träning för mammor | 6
Åsa Nyvall: Yinyoga – vila, reflektion och återhämtning | 8
Sanna Mac Donald: Allt som en gång var | 10
Hans-Olov Öberg, Emil Åreng: Jakten på en perfekt Dry Martini | 12
Niklas Kämpargård: Svemester – Vinter | 14
Erik Martiniussen: Bakteriekriget | 16
Philippa Gregory: Tidvatten | 18
Anna Ihrén: Mästaren | 20
Anna Roos: I mörka vatten | 22
Nadia Hashimi: När natten är som ljusast | 24

pocket
Lisa Förare: Varken | 26
Lina Forss: Kärlek i mån av snö | 26
Anna Lönnqvist: Minns oss som nu | 27
Linwood Barclay: 23 | 27
Candice Fox: Redemption Point | 28
Kristin Fägerskjöld: Klar himmel | 28
Cara Hunter: Ingen utväg | 29
Elisabeth Öhman: Renässansringen | 29
Shubhangi Swarup: Längtans latituder | 30

ANNA-LENA AHLSTRÖM
#hemmamedenbok
Det är märkliga tider. Gatorna är tomma och i kollektivtrafiken rör sig ett fåtal människor. Försiktigt. De fysiska butikerna kämpar med vikande försäljning. Resor begränsas och vi kan inte besöka våra äldre släktingar. Coronapandemin har skakat om oss och fått oss att se världen på ett nytt sätt.
Men det finns ljuspunkter. Tekniken möjliggör att vi kan arbeta hemifrån och ha digitala möten med kollegor och kunder. Samma teknik gör att vi kan vinka till våra nära och kära på skärmen och i viss mån kanske vi har mer kontakt med varandra nu när vi är isolerade.
Vi har också mer tid för underhållning som böcker, serier och sällskapsspel. På förlaget planerar vi höstutgivningen och vi har satt ihop en härlig mix av fakta, spänning och romaner. Efter sommaren drar vi igång med en bok om träning för mammor och en underbar bok om hur du når lugn och harmoni med yinyoga. Vi följer upp vår succébok om Gin & Tonic med Jakten på en perfekt Dry Martini. Och vi får följa med på en chockerande resa i läkemedelsindustrin och lära oss om hur antibiotikaresistenta bakterier hotar att bli vår nästa hälsokatastrof i den hyllade boken Bakteriekriget. Den rådande situationen med begränsning av resor gör Niklas Kämpargårds bok Svemester – Vinter än mer aktuell.
Bland romanerna ser vi två efterlängtade uppföljare, dels Sanna Mac Donalds Allt som en gång var och Nadia Hashimis När natten är som ljusast. Hashimi har rönt stora framgångar internationellt såväl som i Sverige med Pärlan som sprängde sitt skal.
Men ingen mörk höst utan spänning! Vi får återuppta bekantskapen med poliserna Sandra och Dennis i Anna Ihréns Mästaren och i Trosa sänker sig mörkret över ån i den avslutande delen i Anna Roos trilogi Morden vid världens ände.
Ha det bra och stanna hemma med en bok,

HÖST 2020 • LOUISE BÄCKELIN FÖRLAG • 5
Pischa Strindstedt, Paula Rosas:
Mamatastic – träning för mammor
Vardagsinspiration och träningsglädje för nyblivna mammor.
Paula Rosas var tjugoett år gammal när hon blev mamma för första gången. Hur hanterar man alla tankar och rädslor som kommer med att bli mamma? Och hur hittar man tid till träning?
Paula och Pischa träffades när Paula behövde en personlig tränare efter att hon fött sin andra dotter. Med sin berättelse vill de på ett inspirerande och humoristiskt sätt dela med sig av sina erfarenheter och tips till andra mammor, både när det kommer till träning men också i vardagen. Boken innehåller dessutom ett långsiktigt träningsprogram speciellt utformat för mammalivet. Träningsvärk utlovas!
Mamatastic är boken för alla nyblivna mammor som behöver lite hjälp och inspiration på vägen mot att finna balans i vardagen.
PAULA ROSAS är en ständigt trött småbarnsmamma som allt för ofta dricker kaffet kallt. Hon har arbetat med sociala medier och kommunikation i tio år och är en välkänd profil inom familjeliv och hälsa. På Paulas.me driver hon en av Sveriges största bloggar.
PISCHA STRINDSTEDT är personlig tränare och startade 2013 konceptet Wörkout som idag är två gym i Stockholm. Utöver sitt dagliga arbete tränar hon deltagarna i det populära programmet Biggest Loser på TV4 . Hon brinner för träning och hälsa och sprider träningsglädje i sina kanaler på sociala medier under hashtaggen #pischapiskar.
Genre: Träning och hälsa
Omfång: ca 128 sidor
Kartonnage: 978-91-7799-195-3
E-bok: 978-91-7799-198-4
Utkommer: 2020-08-05
6 • LOUISE BÄCKELIN FÖRLAG • HÖST 2020


Träningsvärk utlovas!
Åsa Nyvall:
Yinyoga – vila, reflektion och återhämtning
Varva ner med lugnande yinyoga.
Ien intensiv värld som ställer allt högre krav på prestation, behöver vi tid till vila, återhämtning och reflektion. Det är först när vi stillar oss som vi kan upptäcka vad vi verkligen behöver och hur vi egentligen mår.
Med rofylld yinyoga ger du din kropp och ditt sinne möjlighet att slappna av och vila. Boken innehåller yogapass i olika längder, från 15 minuter till 1,5 timme. Varje pass är utformat efter ett tema, så att du kan ge dig själv det du behöver för stunden. Vill du jobba med din självkänsla och din kroppsuppfattning, samla kraft eller känna mer glädje i livet? Varva ner med yinyoga och fundera över vad du behöver med reflekterande frågor till varje tema.
Alla kan yoga, men positionerna kan se olika ut beroende på vilka förutsättningar din kropp har. Boken ger förslag på alternativa positioner om du till exempel brottas med värk i knän eller axlar.
Yinyoga hjälper din bindväv att mjukna, lindrar värk och ger din kropp och ditt sinne återhämtning och välbehövlig stillhet.
ÅSA NYVALL är yogalärare och har en egen studio i Göteborg. Hon är utbildad samtalsterapeut, parterapeut och samtalscoach och har tidigare gett ut succéboken Kärlekens språk – din guide till lyckliga relationer på LB Förlag, tillsammans med journalisten Helene Arkhem.
Genre: Träning och hälsa
Omfång: ca 128 sidor
Kartonnage: 978-91-7799-221-9
E-bok: 978-91-7799-224-0
Utkommer: 2020-08-12
8 • LOUISE BÄCKELIN FÖRLAG • HÖST 2020


Välbehövlig återhämtning för kropp och sinne.

Sanna Mac Donald:
Allt
som
en gång var
En stark roman om att börja om på nytt, och att våga vara den man egentligen är.
Anna har skilt sig från Mattias och kan äntligen satsa på relationen med Tove, kvinnan hon älskar. Hon borde vara lyckligare än någonsin, men ändå är det något som skaver. Hon sörjer Douglas, sin gammelfarbror. Brevet han lämnade efter sig när han dog, innehåller ledtrådar om vad som hände med hans stora kärlek. Kan sanningen om Douglas ge Anna styrkan att gå vidare med sitt nya liv?
Ingrid har i tjugo års tid drömt om att få vara med Märta, men hon känner skuld över att det är Everts död som gjort deras relation möjlig. Hon kommer ibland på sig själv med att sakna maken. Utan deras äktenskap att gömma sig bakom måste hon finna modet att våga möta omvärlden på ett helt nytt sätt. Årtionden skiljer Anna och Ingrid åt, men deras liv flätas på ett oväntat sätt sam-
man. De påbörjar på varsitt håll en resa mot att våga stå upp för sig själva, och kommer nära sanningar som både smärtar och stärker.
SANNA MAC DONALD arbetar som högstadielärare i svenska och tyska och har i många år föreläst för skolpersonal om hbtq-frågor och normkritisk pedagogik. Allt som en gång var är den efterlängtade uppföljaren till debutromanen Om allt vore annorlunda.
Genre: Skönlitteratur
Omfång: ca 272
Inbunden: 978-91-7799-215-8
E-bok: 978-91-7799-228-8
Utkommer: 2020-09-16
10 • LOUISE BÄCKELIN FÖRLAG • HÖST 2020


»Den efterlängtade uppföljaren till Om allt vore annorlunda.«


Hans-Olov Öberg, Emil Åreng:
Jakten på en perfekt Dry Martini
Av författaren till Världens bästa cocktailbok och Världens bästa ginbok 2019.
Det finns egentligen bara en gindrink i världen som kan utmana Gin & Tonic om världsherraväldet: Dry Martini.
Dry Martini är den eviga klassikern, ikonen bland drinkar med sitt karaktäristiska glas, sin obestridda förstaplats som valet för den världsvane barbesökaren och sin magiska utstrålning som får alla som dricker den att se lite mer välklädda ut. Om Gin & Tonic är drinken för alla, gindrinkarnas partyfixare och en stämningshöjare på glas, är Dry Martini elitisten, som exklusivt väljer ut vilka som får avnjuta dess svalkande och utmanande vågor.
Men hur gör man en perfekt Dry Martini?
HANS-OLOV ÖBERG är författaren bakom den prisbelönta storsäljaren Jakten på en perfekt Gin & Tonic som av Gourmand Awards utsågs till Världens bästa ginbok 2019 i Macao. Boken belönades även med
utmärkelsen Bästa dryckesfoto i Sverige och Bästa cocktailbok i Sverige samma år. Under sina 25 år i finansbranschen fick han tillfälle att resa över hela världen och, såväl i som utanför arbetet, testa de allra bästa barerna.
EMIL ÅRENG är en av Sveriges mest framgångsrika och välkända bartenders. Han utsågs 2016 till Nordens bästa bartender och hans cocktailbok Salongs i Norrland utsågs 2017 till världens bästa cocktailbok i Gourmand Awards. Hans egen version av drycken Gin & Tonic har vunnit utmärkelsen Världens bästa Gin & Tonic. Idag är han kreativt ansvarig för Cadierbaren på Grand Hotel i Stockholm.
Genre: Mat & dryck
Omfång: ca 144 sidor
Kartonnage: 978-91-7799-168-7
E-bok: 978-91-7799-229-5
Utkommer: 2020-09-16
12 • LOUISE BÄCKELIN FÖRLAG • HÖST 2020

 Lär dig göra en Dry Martini i världsklass.
Lär dig göra en Dry Martini i världsklass.

Niklas Kämpargård:
Svemester - Vinter
Mer aktuellt än någonsin.
Klimatförändringarnas effekter får allt fler svenskar att välja bort utlandsresan för att istället upptäcka sitt eget land, och årets Coronautbrott har bidragit till att många semestrar på hemmaplan. Trots att vi stormtrivs under sommaren och helst går i ide under vintern, erbjuder det svenska vinterhalvårets kyla och mörker fantastiska upplevelser som alldeles för få människor tagit del av. Och som dessutom bara går att uppleva i några få länder på jorden.
Tillbringa en natt under stjärnorna, spana efter norrsken, ta en tur på långfärdsskridskor eller i skidspåret, och åk hundspann genom Jämtlands djupa skogar. Det är dags att uppleva Sverige – på vintern.
NIKLAS KÄMPARGÅRD är skribent och fotograf och har skrivit flera böcker om självhushållning, odling och krisberedskap. Han har ett stort intresse för resor och friluftsliv och har tidigare gett ut Svemester: så reser du smart och hållbart i Sverige.
Genre: Guideböcker & resor
Omfång: ca 272 sidor
Danskt band: 978-91-7799-167-0
E-bok: 978-91-7799-227-1
Utkommer: 2020-09-23
14 • LOUISE BÄCKELIN FÖRLAG • HÖST 2020


är dags att uppleva Sverige – på vintern. FOTO: NIKLAS KÄMPARGÅRD
Det
Erik Martiniussen:
Bakteriekriget
Vi står inför den största hälsokatastrofen världen har skådat.
Kan vi bekämpa den?
Varje år dör 700.000 personer av antibiotikaresistenta bakterier världen över. I USA tar resistenta bakterier livet av tre gånger så många människor som HIV och AIDS . Världshälsoorganisationen varnar för att den medicinska vetenskapen kommer att återgå till vad den var för 100 år sedan utan antibiotika. Vi kommer att stå försvarslösa mot vanliga infektioner och enkla ingrepp blir omöjliga att utföra. Innan år 2050 kommer 10 miljoner människors liv att vara i fara varje år. Den största hälsokatastrofen världen har skådat står för vår tröskel, ändå är det knappt någon som talar om den.
Bakteriekriget avslöjar det cheferna för läkemedelsindustrin, sjukhusen och köttindustrin inte vill att du ska veta. Det är chockerande uppgifter om hur jakten på vinst har drivit läkemedelsindustrin till att distribuera antibiotika som om det vore vitaminer, och om hur köttindustrin sys-
tematiskt undanhållit information om en omfattande användning av antibiotika inom lantbruket.
Djur och bakterier har i hundratusentals år levt i en balans som den obegränsade konsumtionen av antibiotika nu hotar att sätta ur spel. Finns det något hopp kvar? Ett gammalt botemedel, bevarat av läkare och sjuksköterskor i Georgien, är på väg att återupptäckas och det kan komma att ändra den medicinska historien – igen.
ERIK MARTINIUSSEN är en norsk journalist och författare. Han har tidigare skrivit boken Drivhuseffekten.
Genre: Medicin & hälsa
Originaltitel: Bakteriekrigen
Översättning: Joachim Retzlaff
Omfång: ca 400 sidor
Inbunden: 978-91-7799-222-6
E-bok: 978-91-7799-230-1
Utkommer: 2020-09-23
16 • LOUISE BÄCKELIN FÖRLAG • HÖST 2020


Finns det något hopp kvar?
Philippa Gregory: Tidvatten
England 1648. En farlig tid för en kvinna att vara annorlunda.
Det är midsommarafton 1648 och England är mitt uppe i ett inbördeskrig mellan den lömske kung Karl I och det rebelliska parlamentet. Konflikten sträcker sig till de mest avlägsna delarna av landet, ända till tidvattenområdena i söder.
Alinor kommer från en lång rad av läkekvinnor. I ett sista försök att bryta sig loss från sin våldsamme make står hon en natt under fullmånen på en kyrkogård, och väntar på en vålnad som ska uttala orden som befriar henne. Men istället möter hon James, en ung man på rymmen, och visar honom vägen genom tidvattenområdets förrädiska landskap. Bortom allt förnuft faller de handlöst för varandra.
I en tid av oro och vidskepelse skapar Alinors kunskaper om läkekonst och örter
misstanke hos befolkningen i den lilla byn, och hennes skönhet och ambition väcker avund. Snart tar rädslan och avundsjukan över, och byborna bestämmer sig för att ta saken i egna händer.
PHILIPPA GREGORY är en brittisk författare och historiker och har skrivit den berömda romanen Den andra systern Boleyn, som blivit film med Natalie Portman och Scarlett Johansson i rollerna.
Genre: Utländsk skönlitteratur
Originaltitel: Tidelands
Översättning: Annika Sundberg
Omfång: ca 400 sidor
Inbunden: 978-91-7799-138-0
E-bok: 978-91-7799-139-7
Utkommer: 2020-10-21
18 • LOUISE BÄCKELIN FÖRLAG • HÖST 2020

ENGLAND 1648. EN FARLIG TID FÖR EN KVINNA ATT VARA ANNORLUNDA.
PhiliPPa GREGORY
TIDVATTEN
“… det här är Gregory när hon är som bäst” KIRKUS REVIEWS

Av författaren till Den andra systern Boleyn.

Anna Ihrén: Mästaren
Ännu ett mord skakar Göteborg och spåren leder ända till 80-talets Berlin.
Högst upp på taket till Göteborgs första skyskrapa hittas byggmästaren Ernst Rosbäck död. Bygget är ett prestigeprojekt för den snart 400 år gamla staden och poliskommissarie Dennis Wilhelmson och hans kollegor har nu allas ögon på sig. Inte minst politikernas, som pressar dem att lösa mordet. Byggmästarens barnbarn, fjorton år gamla Nadja, är dessutom försvunnen sedan flera månader tillbaka och polisen har ännu inte hittat några spår efter henne.
Sandra Haraldsson är tillbaka på arbetet efter en lång sjukskrivning. Hon är utbränd sedan de fruktansvärda händelserna i den gamla källaren på mentalsjukhuset Sankt Jörgen. Sandra kämpar mot tröttheten och tårarna som hela tiden tränger sig på. Hennes chef Camilla Stålberg är minst sagt splittrad eftersom hon och flickvännen Cleuda har allvarliga problem i relationen och det påverkar alla som kommer i chefens väg.
Vem mördade byggmästaren och varför? Utredningen står stilla, men så får polisen upp ett spår som leder till Berlin och gruppen Alphavilles gamla låtar från 1984. Men deras framsteg stoppas snart av virussjukdomen Corona, som härjar skoningslöst i Europa.
ANNA IHRÉN är författaren bakom succéserien Morden på Smögen. Mästaren är den tredje fristående delen i Jubileumsserien, som speglar de utmaningar Göteborg står inför när staden fyller 400 år, 2021. Nattvakten är den första delen och Maskmakaren den andra.
Genre: Deckare & spänning
Omfång: ca 256 sidor
Inbunden: 978-91-7799-231-8
E-bok: 978-91-7799-232-5
Utkommer: 2020-10-21
20 • LOUISE BÄCKELIN FÖRLAG • HÖST 2020

 Tredje fristående delen i Jubileumsserien.
Tredje fristående delen i Jubileumsserien.

Anna Roos:
I mörka vatten
Sista fristående delen i trilogin om Morden vid världens ände.
Regn piskar marken och fyller den porösa gyttjan med små hål. Trädens grenar har trasslat in sig i varandra och hindrar både djur och människor från att passera. Under eftermiddagen har skogen varit fylld av folk. Nu håller kylan dem borta och den enda som gömmer sig i skogen är personen som alla letar efter, vars stela fingrar skymtar i det mörka vattnet.
Hösten är i antågande och träden längs Trosaån har färgats vackert gula. Äntligen har Vera Jansson hittat en köpare till sitt barndomshem, och köpeskillingen är tillräcklig för att hon ska kunna bli delägare i revisionsbolaget hon arbetar för. Allt hon behöver göra är att signera kontraktet för att kunna lämna sitt förflutna bakom sig.
Men så försvinner sonen till en av hennes vänner spårlöst, och Vera släpper allt för att hjälpa stadens invånare att leta. Omgående
dras paralleller till Veras brors försvinnande för många år sedan, och mörkret hon gjort allt för att skingra sänker sig åter över husen vid ån.
ANNA ROOS är civilekonom och har studerat vid Handelshögskolan i Stockholm. Tidigare har hon arbetat på kasino och var under en tid bosatt i Atlanta i USA . I mörka vatten är den tredje och avslutande delen i spänningstrilogin om Morden vid världens ände. Lika i döden är den första och En evig sömn den andra.
Genre: Deckare & spänning
Omfång: ca 256 sidor
Inbunden: 978-91-7799-132-8
E-bok: 978-91-7799-133-5
Utkommer: 2020-10-28
22 • LOUISE BÄCKELIN FÖRLAG • HÖST 2020
ELLINOR KODA

»Så bra att jag blir arg… vill ju läsa fortsättningen genast.«
Lotta Olsson om Lika i döden


Nadia Hashimi:
När natten är som ljusast
Av författaren till Pärlan som sprängde sitt skal.
Fereiba har aldrig upplevt en större kärlek än den till hennes make, Mahmoud, och deras familj. De lever ett lyckligt medelklassliv i Afghanistan med utbildning och välbetalda arbeten.
Men deras liv förändras hastigt när krig utbryter och talibanerna tar över makten i landet. Mahmoud, som är civilingenjör, blir måltavla för den nya fundamentalistiska regimen och mördas. Fereiba tvingas fly Kabul med deras tre barn och har bara en chans att överleva: hon måste ta sig till sin syster i England.
Med förfalskade papper påbörjar Fereiba en farlig flykt genom Afghanistan. Utmattad och förkrossad lyckas hon, dold av nattens mörker, ta sin familj över gränsen till Iran och hela vägen till Grekland. Men bland folkmassorna på en stimmig marknad försvinner plötsligt hennes tonårsson, Saleem, från resten av familjen. Fereiba står inför ett omöjligt val, men fortsätter flykten för
att rädda de andra medan Saleem dras ned i en mörk undre värld bland papperslösa afghaner som härjar på Europas gator. På varsin sida av kontinenten kämpar Fereiba och Saleem för att nå varandra och för att finna en plats där de kan börja om på nytt.
NADIA HASHIMI är en afghansk-amerikansk författare och barnläkare som bor i Maryland. Hennes debutroman, Pärlan som sprängde sitt skal, har gjort succé över hela världen.
Genre: Utländsk skönlitteratur
Originaltitel: When the Moon is Low
Översättning: Boel Unnerstad
Omfång: ca 350 sidor
Inbunden: 978-91-7799-240-0
E-bok: 978-91-7799-241-7
Utkommer: 2020-11-04
24 • LOUISE BÄCKELIN FÖRLAG • HÖST 2020
CHRIS CARTER


”Ett måste att läsa, om gränser och en stark moders kamp att ta sig över dem.”
O, THE OPRAH MAGAZINE

Pocket

Lisa Förare Varken
»Lisa Förare bygger en intensivt doftande förortsfantasyvärld med säker hand. Varken är en stort underhållande och imponerande debut.«
Malin Krutmeijer , Aftonbladet
»Förares språk är personligt och målande och hela historien skruvad och spännande.«
BTJ
Genre: Deckare & spänning
Omfång: 461 sidor
Pocket: 978-91-7799-182-3
E-bok: 978-91-7799-087-1
Utkommer: 2020-09-16

Lina Forss Kärlek i mån av snö
»Men vilken mysig bok. Den perfekta uppvärmningen inför vinter och jul!«
Bokdjungeln
»Mysig bladvändare man blir glad av.«
I min bokhylla
Genre: Feelgood
Omfång: 256 sidor
Pocket: 978-91-7799-233-2
E-bok: 978-91-7799-054-3
Utkommer: 2020-09-16
HÖST 2020 • LOUISE BÄCKELIN FÖRLAG • 27

Anna Lönnqvist Minns oss som nu
»Vintergnistrande naturskildringar och hänförande förälskelser, Anna Lönnqvist har skrivit ännu en förtjusande kärleksroman fylld av bitterljuvt vemod men också åtrå och hetta.«
Breakfast Book Club
»Anna Lönnqvist kan verkligen det här med romantik. Betyg 5 av 5.«
Genre: Feelgood
Carinas läsdagbok
Omfång: 384 sidor
Pocket: 978-91-7799-234-9
E-bok: 978-91-7799-153-3
Utkommer: 2020-10-14

Candice Fox Redemption Point
»En nervkittlande thriller som håller läsaren i ett järngrepp.«
Kajsa Banck, BTJ
»En effektiv, obehagligt trovärdig nagelbitarthriller.«
Lotta Olsson, DN
Genre: Deckare & spänning
Originaltitel: Redemption Point
Översättning: Hanna Axén
Omfång: 416 sidor
Pocket: 978-91-7799-236-3
E-bok: 978-91-7799-145-8
Utkommer: 2020-11-18
28 • LOUISE BÄCKELIN FÖRLAG • HÖST 2020
POCKET

Kristin Fägerskjöld
Klar himmel
»Klar himmel går direkt in på min topp tre-lista 2020! Så intressant, spännande, välskriven och bra.«
BibbloAgneta
»Underbar, trovärdig och gripande.«
Bettan bokprataren
Genre: Skönlitteratur
Omfång: 400 sidor
Pocket: 978-91-7799-237-0
E-bok: 978-91-7799-163-2
Utkommer: 2020-11-18

Cara Hunter
Ingen utväg
»Det här sticker ut – slå till! Läs den här!«
Titti Schultz, Go’kväll
»Skickligt berättar [ Cara Hunter] om alla vardagskonflikter som bubblar under ytan även i skenbart lyckliga familjer.«
Lotta Olsson, DN
Genre: Deckare & spänning
Originaltitel: No Way Out
Översättning: Jan Risheden
Omfång: 336 sidor
Pocket: 978-91-7799-238-7
E-bok: 978-91-7799-143-4
Utkommer: 2020-12-16
HÖST 2020 • LOUISE BÄCKELIN FÖRLAG • 29 POCKET


Elisabeth Öhman
Renässansringen
»Renässansringen är en påhittig spänningsroman fylld av fantasi och berättarglädje«
BTJ
»En roande och omväxlande tidsresa in i de mest osannolika miljöer.«
Ölandsbladet
Genre: Skönlitteratur
Omfång: 240 sidor
Pocket: 978-91-7799-192-2
E-bok: 978-91-8884-543-6
Utkommer: 2020-12-16
Shubhangi Swarup Längtans latituder
»Den råa styrkan i Shubhangi Swarups fantasi och poetiska språkbruk är förtrollande och förtjänar att hyllas.«
Telegraph India
»Shubhangi Swarup har ett målande språk och en alldeles unik och annorlunda berättarröst. Längtans latituder är en bok att förtrollas av.« I min bokhylla
Genre: Utländsk skönlitteratur
Originaltitel: Latitudes of Longing
Översättning: Birgitta Wernbro Augustsson
Omfång: 336 sidor
Pocket: 978-91-7799-239-4
E-bok: 978-91-7799-097-0
Utkommer: 2020-12-16
30 • LOUISE BÄCKELIN FÖRLAG • HÖST 2020 POCKET
Arrivederci!




LOUISE BÄCKELIN FÖRLAG
VÄSTMANNAGATAN 24
113 60 STOCKHOLM
WWW.LBFORLAG.SE
LOUISEBACKELINFORLAG
LOUISEBACKELINFORLAG
LOUISE BÄCKELIN
VD & FÖRLÄGGARE
LOUISE@LBFORLAG.SE
070-616 67 66
CAMILLA MOLIN
SÄLJ & MARKNAD
CAMILLA@LBFORLAG.SE
070-172 47 97

EMMA ANDERSSON
FÖRLAGSKOORDINATOR
EMMA@LBFORLAG.SE
070-511 32 45
 LOUISE BÄCKELIN FÖRLAG
LOUISE BÄCKELIN FÖRLAG















 Lär dig göra en Dry Martini i världsklass.
Lär dig göra en Dry Martini i världsklass.

Tredje fristående delen i Jubileumsserien.
Tredje fristående delen i Jubileumsserien.



















